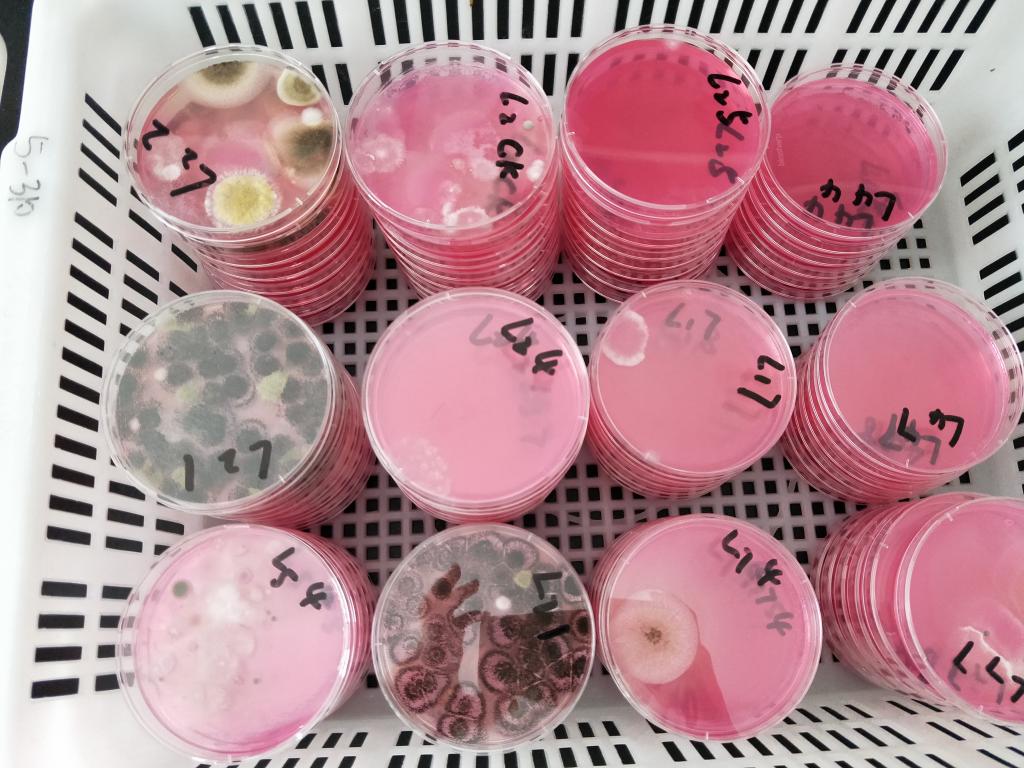

七月二十三日,tyc5997太阳集团老区第五教学楼,辣椒粉射频工艺小队的6名同学将在这里进行为期10天的微生物实验实践活动。
在此前一个月的时间里,该团队已经修改并完善了实验设计及操作方案,为活动准备好了初期工作。在活动期间,团队认真仔细地完成了各步工作,杀菌,接菌,培养,微生物各项理化性质的检测。杀菌工作前需要用报纸包好各种实验器材,试管、烧杯、培养皿、培养基、枪头。接菌中同学们仔细地接种和进行标记也很注重规范操作,防止培养基受到杂菌地污染。培养时,要保证良好的无菌环境,并且需要耐心等待,在等待过程中,也继续做着实验的其他各项工作。令人印象深刻的是最后检验过程中进行的干燥曲线的测定、水分活度的测定以及射频工艺的杀菌等具有开拓思维以及丰富知识作用的多项操作。在试验结束之后,团队成员也进行了整个实验的汇报和总结报告。
活动结束后,谈到活动的意义时,队长说到:“进行实验操作的目的就是锻炼食品人的实际操作能力,和塑造专业精神。”大家在实际操作的过程中也对书本上的知识进行了巩固和实践。
经交流得知,团队各个成员,会在之后的学习生活中,投入更多精力在实验上,进一步培养自己的专业意识与素养。将专业与生活结合起来,把创新立于实践中,即使是枯燥的实验,也能在坚持与琢磨中收获满满的成果。